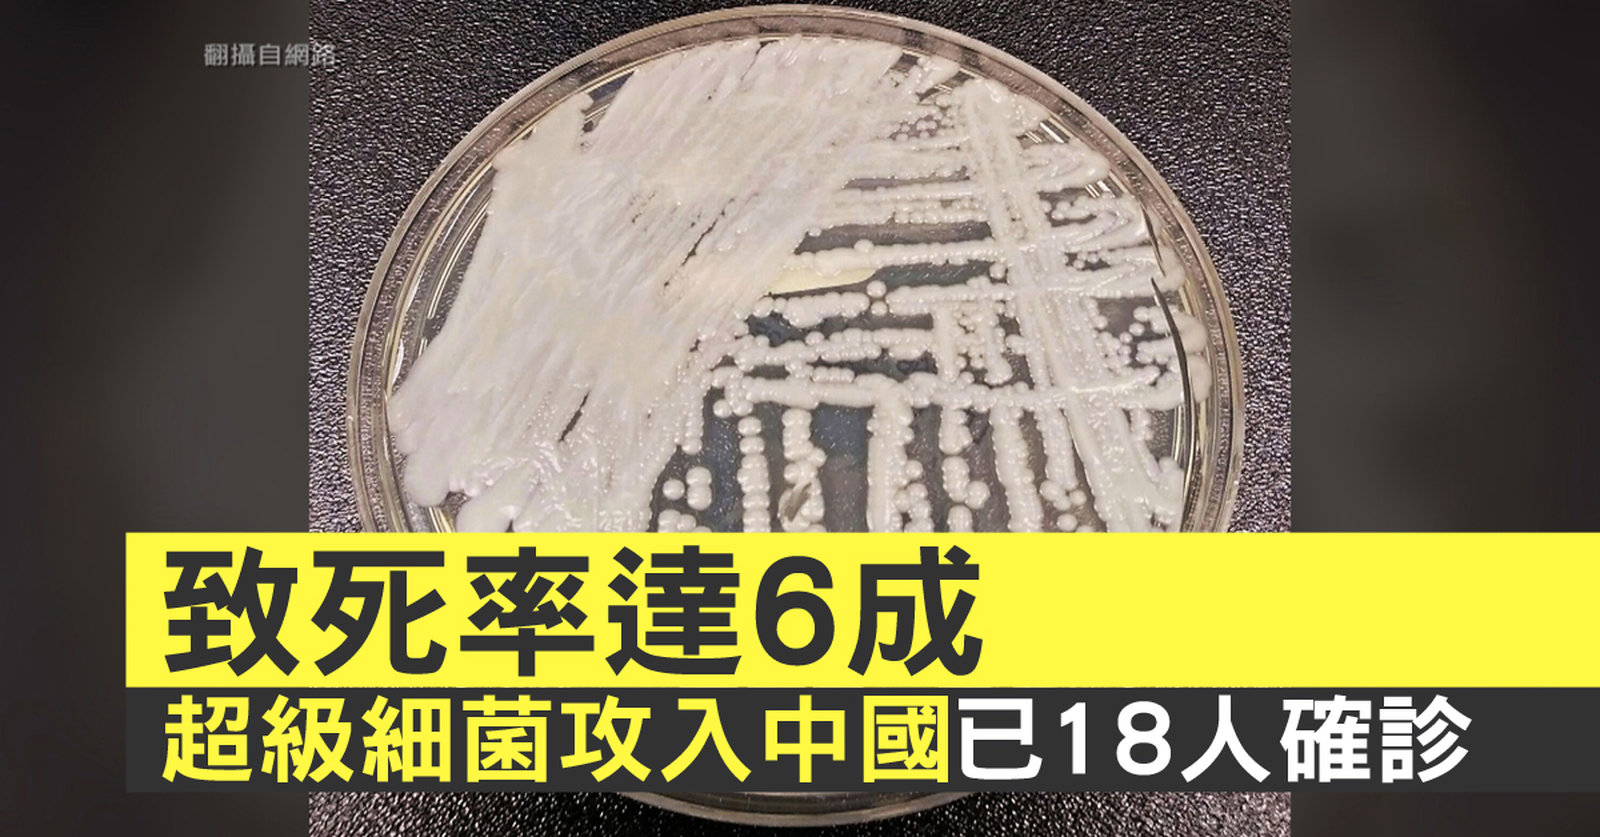

-
 港傘運九子案罪成 籲續爭民主對抗暴政!
港傘運九子案罪成 籲續爭民主對抗暴政!
2014年一場持續79日的雨傘運動令國際注目港人的和平理性抗爭的精神,不過香港法院星期二裁定佔中九子案的全部被告罪名成立。他們強調為公義抗爭無怨無悔,呼籲港人繼續爭取民主對抗中共暴政。 //asset3.ntdtv.com.tw/public/uploads/assets/2019/04/09/2019-04-09-5cac8b68bdada.mp4 香港|佔中九子案|雨傘運動2019-04-09 20:17:01
-
 中共不願承諾開放市場 歐盟對中立場漸強硬
中共不願承諾開放市場 歐盟對中立場漸強硬
好,我們接著帶您關心,歐盟與中國,今天在布魯塞爾舉行峰會,中國總理李克強將和歐盟委員會主席榮科,以及歐盟理事會主席,就貿易、投資和市場議題,舉行會面。值得注意的是,在高峰會前夕,有歐盟貿易專員表示,歐中投資協定談判,雖然已經進行了五年 ,但北京當局遲遲不願承諾開放市場,因此有歐洲媒體研判,歐盟對中立場,將會日趨強硬。 //asset3.ntdtv.com.tw/public/uploads/assets/2019/04/09/2019-04-09-5cac8b9076736.mp4 歐中峰會|歐洲|中國|中共2019-04-09 20:07:00
-
 美中談判 白宮官員:雖有進展 仍不滿意
美中談判 白宮官員:雖有進展 仍不滿意
接著關心,美中貿易的最新進展。路透社報導,美國白宮官員表示,儘管美中雙方,在一連串問題上有所進展,但對一些議題,仍舊不滿意。 //asset3.ntdtv.com.tw/public/uploads/assets/2019/04/09/2019-04-09-5cac8bb5ace89.mp4 美中貿易戰2019-04-09 20:08:57
-
 因應貿易戰 六成美跨國公司移轉中國供應鏈
因應貿易戰 六成美跨國公司移轉中國供應鏈
好,美中貿易戰影響,國際管理顧問公司最新調查顯示,有高達六成的美國跨國公司,已經開始轉移他們在中國大陸的供應鏈。 //asset3.ntdtv.com.tw/public/uploads/assets/2019/04/09/2019-04-09-5cac8c6147c1f.mp4 貿易戰|供應鏈|撤出中國2019-04-09 20:09:54
-
 台商回流潮!蘇揆:落葉歸根讓台灣根基茁壯
台商回流潮!蘇揆:落葉歸根讓台灣根基茁壯
好,全球供應鏈,正在因為美中貿易戰,重新洗牌。而台商回流潮,也是持續發酵,政院表示,到這個月底將有30家廠商返台投資,投資金額破台幣一千億元。行政院長蘇貞昌關心回台投資企業,上午到新竹參訪網通廠智邦科技,蘇貞昌表示,好的企業回到台灣,落葉歸根,讓台灣根基茁壯。 //asset3.ntdtv.com.tw/public/uploads/assets/2019/04/09/2019-04-09-5cac8c8989f8c.mp4 蘇貞昌|智邦|網通|台商回流|五缺2019-04-09 20:12:04
-
 蔡英文喊話合作 賴清德重申走完初選
蔡英文喊話合作 賴清德重申走完初選
再來關心,今天台灣政壇的焦點新聞,民進黨總統初選協調至今仍然沒有結果,昨天(8日)總統蔡英文和前院長賴清德,雖然展開首次協調會面,但雙方沒有交集。蔡英文今天(9日)表示,民進黨應該以勝選為目標,不要因為初選而撕裂。不過賴清德隨後,在下午記者會上,也再次表明要完成初選,強調如果蔡英文勝出,他會全力輔選,反之,賴清德也希望蔡英文,能表達同樣的態度。 //asset3.ntdtv.com.tw/public/uploads/assets/2019/04/09/2019-04-09-5cac8daa5a61f.mp4 蔡英文|民進黨|總統初選|賴清德2019-04-09 20:18:53
-
 民團憂民主巨變 籲藍綠總統提名納公民對話
民團憂民主巨變 籲藍綠總統提名納公民對話
好,距離明年總統大選,只剩不到300天,民進黨以及國民黨,目前都仍陷在黨內初選的爭議中。那麼今天(9日),有民間團體在立法院大門前,表達希望藍綠兩黨的總統提名初選程序,納入公民對話,因為2020將是台灣民主能否延續 關鍵的一年。 //asset1.ntdtv.com.tw/public/uploads/assets/2019/04/09/2019-04-09-5cac8dd3427e4.mp4 經濟民主連合|公民陣線|徐偉群|賴中強|沈伯洋|選舉|公民對話|民主2019-04-17 21:41:04
-
 致死率達6成 超級細菌攻入中國已18人確診
致死率達6成 超級細菌攻入中國已18人確診
為您插播一則消息。美國出現高抗藥性超級真菌「耳念珠菌」,致死率高達60%,聯邦疾病防治中心(CDC)列入構成「緊急威脅」的細菌名單。專家表示,目前為止,中國已確認18起超級真菌臨床感染病例。專家表示,「超級真菌能長時間存活於患者和醫護人員的皮膚及醫院設施表面,如果感染控制措施不力,容易導致院內爆發性感染」。紐約時報先前報導,具多重抗藥性、足以致死的耳念珠菌,有近半數病例在90天內死亡,致命威脅引發醫界憂慮。研究人員普遍認為,這是新近進化出來的、快速適應人體宿主環境能力的新物種,主要引起血液感染,致死率高達 //asset2.ntdtv.com.tw/public/uploads/assets/2019/04/09/2019-04-09-5cac8de8ad86d.mp4 超級真菌|耳念珠菌|致死率|中國2019-04-09 20:17:56
-
 微軟IDC公布AI關鍵報告 台灣企業輸在保守文化
微軟IDC公布AI關鍵報告 台灣企業輸在保守文化
科技大廠看好人工智慧產業趨勢,紛紛加碼投資。IDC 與微軟,今天共同舉辦盛大活動,更首度公布 AI產業關鍵 報告,點名台灣企業導入AI後,極具成長潛力,但最大阻礙,來自普遍保守、不願嘗試的企業文化,恐怕阻礙台灣企業的數位轉型腳步。 //asset2.ntdtv.com.tw/public/uploads/assets/2019/04/09/2019-04-09-5cac8ecdc05ce.mp4 AI|數位轉型|人工智慧|IDC2019-04-09 20:21:31
-
 憂美國演講表現失常 韓國瑜訪美提前一天
憂美國演講表現失常 韓國瑜訪美提前一天
歡迎回來,高雄市長韓國瑜原定10日訪美行程,已經確定將提早到今天(9日)深夜出發,韓國瑜是為了準備哈佛大學演講稿,避免表現失常,所以提早飛往美國。 //asset2.ntdtv.com.tw/public/uploads/assets/2019/04/09/2019-04-09-5cac8fe7c8274.mp4 韓國瑜|美國|哈佛大學|演講|高雄2019-04-09 20:25:56
-
 兩岸人民關係條例三讀 中資違法來台可罰2500萬
兩岸人民關係條例三讀 中資違法來台可罰2500萬
為了遏止中資來台非法投資,立法院,今天三讀通過,「兩岸人民關係條例修正案」,非法中資來台,最高罰鍰,從60萬,提高到2500萬元,陸委會也表態,後續將由主管機關訂定裁罰基準。 //asset1.ntdtv.com.tw/public/uploads/assets/2019/04/09/2019-04-09-5cac900d7d78f.mp4 兩岸人民關係條例|陸資|中資|大同|黃國昌2019-04-09 20:27:56
-
 沒有暫緩軍售!美軍方公告對台軍售合約
沒有暫緩軍售!美軍方公告對台軍售合約
再來帶您來看到,有報導稱美國總統川普,為了貿易戰談判要暫緩對台軍售,不過,美國國防部日前公告,軍火商雷神公司,得標一份總額5千萬美金(FMS)的合約,也涉及了對台軍售。中華民國國防部海軍司令部指出,這份合約是屬於美方專案管理行政作業模式。而中華民國國軍也依「國軍採購作業規定」,循軍購管道委請美方,執行基隆級艦 對空雷達天線維修保養,及技術支援服務,採購金額約570萬美元,以維持裝備妥善,確保海軍戰力,護衛海疆。 //asset2.ntdtv.com.tw/public/uploads/assets/2019/04/09/2019-04-09-5cac901f5c5f1.mp4 美國|軍售|美台關係|中華民國|主權2019-04-09 20:28:39
-
 台立委:中共假新聞武器化 盼台美全方位合作
台立委:中共假新聞武器化 盼台美全方位合作
美台持續友好,再來看到,台美國會議員聯誼會會長蕭美琴,週一(8日)出席美國智庫研討會受訪表示,中共把假新聞武器化,台美應該全方位合作。美國智庫研究員馬明漢認為,台美需要在安全、經濟、價值合作,啟動印太民主諮商機制,是非常好的進展。至於F16V軍售案被擱置的傳言,馬明漢認為 證據不足。 //asset1.ntdtv.com.tw/public/uploads/assets/2019/04/09/2019-04-09-5cac9123cca42.mp4 美台關係|中共訊息戰|假新聞武器|美國智庫|台美關係|民主防衛2019-04-11 12:57:22
-
 公車Wi-Fi用華為 學者籲設專法防境外滲透
公車Wi-Fi用華為 學者籲設專法防境外滲透
持續帶您關心,中國設備大廠華為,這幾年因為資安疑慮遭國際抵制。現在傳出,新北市部分公車提供的免費WI-FI,竟使用華為設備。學者提醒,恐怕有資安疑慮,呼籲政府訂定專法,來訪堵境外勢力。 //asset2.ntdtv.com.tw/public/uploads/assets/2019/04/09/2019-04-09-5cac914cc6099.mp4 華為|wifi|公車|資安|中共|新北市2019-04-09 20:40:28
-
 中共強拆千年古寺 18米巨佛慘遭斬首|中國一分鐘
中共強拆千年古寺 18米巨佛慘遭斬首|中國一分鐘
//asset2.ntdtv.com.tw/public/uploads/assets/2019/04/09/2019-04-09-5cac9165040e3.mp4 2019-04-09 20:34:08
-
 一國兩制?港作家倪匡:共產黨哪能信
一國兩制?港作家倪匡:共產黨哪能信
83歲的香港知名作家倪匡,是港星周慧敏丈夫倪震的父親。他日前接受香港電台《鏗鏘說》訪問時表示,自己根本就不相信「一國兩制」,還說,共產黨幾十年來沒有一句話兌現過。 //asset2.ntdtv.com.tw/public/uploads/assets/2019/04/09/2019-04-09-5cac9246e3972.mp4 倪匡|四大才子|一國兩制2019-04-09 20:35:51
-
 嘲諷時政視為「行為不端」中共封殺歌手
嘲諷時政視為「行為不端」中共封殺歌手
中國真相報導,帶您繼續來看到,擁有龐大粉絲群的大陸獨立音樂人李志,原定在四川舉辦的23場個人巡演,遭當局封殺,理由竟然是李志「行為不端」。李志曾經創作紀念1989年天安門事件的相關歌曲,今年是六四事件30周年,隨著李志的演唱會被封殺,也算是反向的幫這些歌曲 做了宣傳。 //asset1.ntdtv.com.tw/public/uploads/assets/2019/04/09/2019-04-09-5cac9aa251c23.mp4 大陸獨立音樂人|李志|四川巡演|封殺|89六四|天安門事件2019-04-09 21:14:11
-
 力阻硬脫歐!英國會立新法 梅伊會德法領袖
力阻硬脫歐!英國會立新法 梅伊會德法領袖
歡迎回來。英國是否會走上無協議脫歐,已經進入倒數計時,將在明天,星期三(10日)的歐盟峰會後,就會揭曉。而英國國會在昨天(8日)通過新法,強制政府必須先向歐盟提出展延要求,而首相梅伊也將在峰會召開前,與德法兩國領袖會面,爭取支持,全力避免硬脫歐。 //asset1.ntdtv.com.tw/public/uploads/assets/2019/04/09/2019-04-09-5cac94a321274.mp4 梅伊|英國脫歐|硬脫歐|無協議脫歐|歐盟2019-04-09 20:44:06
-
 中共投資德國城市 地方官:不做斯里蘭卡第二|寰宇掃描
中共投資德國城市 地方官:不做斯里蘭卡第二|寰宇掃描
//asset2.ntdtv.com.tw/public/uploads/assets/2019/04/09/2019-04-09-5cac94bbbfd8a.mp4 2019-04-09 20:45:12
-
 世界首創!國研院開發晶圓級氣體感測系統
世界首創!國研院開發晶圓級氣體感測系統
科技趨勢新聞,帶您來看到,AIoT時代,感測器扮演舉足輕重的角色,國研院發表全球首創「晶圓級氣體感測器高效能點測系統」,在晶圓階段,就可以測試氣體感測器(感測晶片)效能,大幅縮短檢測時間,而且在封裝前,就能得知每顆晶片的品質與分級,避免資源浪費。 //asset1.ntdtv.com.tw/public/uploads/assets/2019/04/09/2019-04-09-5cac9acaed5c8.mp4 AIoT|感測器|國研院|氣體感測器|半導體2019-04-09 21:14:52
-
 企業CEO:神韻的善深入人心 盼傳遍世界
企業CEO:神韻的善深入人心 盼傳遍世界
歡迎回來。美國神韻世界藝術團,昨天(7日)午間在高雄文化中心,最後一場演出,持續座無虛席,佳評如潮。科技公司執行長讚美,神韻善的力量,深入他與家人的心,他說,這麼好的演出應該讓世界都知道,特別是華人地區。 //asset2.ntdtv.com.tw/public/uploads/assets/2019/04/09/2019-04-09-5cac96fb0d2c5.mp4 2019神韻報導|神韻世界藝術團|神韻|神韻藝術團|高雄2019-04-09 20:52:59
-
 基隆嶼國際磯釣賽 日本磯釣好手將來台獻技
基隆嶼國際磯釣賽 日本磯釣好手將來台獻技
磯釣是近年亞洲國家盛行的釣魚活動,台灣也搭上這股風潮,由基隆市政府舉辦的第二屆基隆嶼國際磯釣賽,將在這個星期六(13日)登場,連續舉辦2天,今天(9日)舉行宣傳記者會,市長林右昌宣布共有60位好手參賽,包括日本磯釣界重量級磯釣好手田中貴以及山元隆史,都將來台獻技。 //asset2.ntdtv.com.tw/public/uploads/assets/2019/04/09/2019-04-09-5cac9728265b7.mp4 基隆嶼國際磯釣賽|磯釣賽|林右昌|沈文程|蔣珮雯|台灣龍珠2019-04-09 21:14:10
-
 與館長直播談司改 賴清德:要讓恐龍下台
與館長直播談司改 賴清德:要讓恐龍下台
前行政院長賴清德,在今天下午召開記者會,重申堅持走完民進黨總統初選程序的態度,隨後,晚間八點,賴清德接受邀請,與台灣網紅「館長」陳之漢一起直播,除了談到幫助中小企業的問題,還問到阿扁特赦的問題,賴清德認為這是台灣司法制度有問題,他如果有機會當總統,一定會在司法改革上作出努力。 //asset2.ntdtv.com.tw/public/uploads/assets/2019/04/09/2019-04-09-5cac9749efcf7.mp4 賴清德|直播|館長|飆悍|陳之漢|總統2019-04-09 20:56:58
-
 4月10日天氣預報
4月10日天氣預報
接著帶您來看到4月10日的天氣預報。 //asset2.ntdtv.com.tw/public/uploads/assets/2019/04/09/2019-04-09-5cac976d05497.mp4 2019-04-09 20:58:29
-
 長榮勞資協商進展有限 17日再談
長榮勞資協商進展有限 17日再談
桃園空服員職業工會會與資方今天(9日)進行第二度勞資協商,工會提出4項訴求「調高外站津貼」、「改善過勞航班」、「落實產業民主改善專制管理」、「堅持禁搭便車、力爭工會自主」,希望資方正面回應,不過,雙方並未達成共識,17日再繼續第三次協商。 //asset2.ntdtv.com.tw/public/uploads/assets/2019/04/09/2019-04-09-5cac9ae2b8ccd.mp4 長榮勞資協商|空服員工會|過勞航班|桃園2019-04-09 21:13:25
-
 力拱韓國瑜?藍營基層醞釀徵召
力拱韓國瑜?藍營基層醞釀徵召
再來看到,國民黨初選風波是越演越烈,基層醞釀要連署,要求黨中央4月底就開黨代表大會,提早徵召韓國瑜。 //asset1.ntdtv.com.tw/public/uploads/assets/2019/04/09/2019-04-09-5cac9afe94321.mp4 國民黨初選|黨內初選|韓國瑜|王金平|朱立倫2019-04-09 21:14:40
-
 神韻墨城大爆滿 著名演員感動無以言表
神韻墨城大爆滿 著名演員感動無以言表
4月6日,美國神韻巡迴藝術團,在墨西哥城國家禮堂的兩場演出,吸引了九千人前來觀賞,場面壯觀。墨西哥著名女演員拉奎爾·奧爾梅多,被演出感動落淚。 //asset2.ntdtv.com.tw/public/uploads/assets/2019/04/09/2019-04-09-5cac9bb342015.mp4 美國神韻巡迴藝術團|墨西哥|Raquel|Olmedo2019-04-12 12:58:34
-
 美對台軍售 學者:隨送隨審象徵視台為盟邦|台灣速速看
美對台軍售 學者:隨送隨審象徵視台為盟邦|台灣速速看
//asset1.ntdtv.com.tw/public/uploads/assets/2019/04/09/2019-04-09-5cac9bce2a9f1.mp4 2019-04-09 21:18:25
-
 反制洗腦 破解學習強國軟件 免費上GitHub
反制洗腦 破解學習強國軟件 免費上GitHub
中共中宣部年初推出網路軟件「學習強國APP」,並透過積分制,強迫所有黨員和公務員學習。為抵制洗腦,針對這款APP的「破解」軟件也紛紛出爐,其中一款最近被掛上程式碼託管平臺「GitHub」,令中共一時間無可奈何。 //asset3.ntdtv.com.tw/public/uploads/assets/2019/04/09/2019-04-09-5cac9e7d93aef.mp4 中共|中宣部|學習強國APP|洗腦|破解|GitHub2019-04-09 21:19:30
-
 買粉絲團招網紅 中共下手臺總統大選?
買粉絲團招網紅 中共下手臺總統大選?
最近,臺灣有很多臉書粉絲團收到私訊,要求進行購買經營權。與此同時,在臉書和一些網站上,出現不少尋找所謂「支持兩岸統一」的網紅的招人信息。人們質疑,中共正在布局網路部隊,試圖影響明年初的臺灣總統大選。請看報導。 //asset3.ntdtv.com.tw/public/uploads/assets/2019/04/09/2019-04-09-5caca1ef8fa12.mp4 臉書粉絲團|購買經營權|網紅|中共網戰|統戰|臺灣總統大選2019-04-09 21:35:35
-
 超商搶高溫商機 冰品出籠要民眾透心涼!
超商搶高溫商機 冰品出籠要民眾透心涼!
這幾天,氣溫超過30度,也帶動冰品的銷量,像是冰淇淋店外頭大排長龍,還賣起繽紛的馬卡龍冰淇淋和銅鑼燒冰淇淋,超商業者也不甘示弱,把一串要價3000元的日本麝香葡萄變成冰棒。甚至引進日韓冰品,要搶高溫商機。 //asset1.ntdtv.com.tw/public/uploads/assets/2019/04/09/2019-04-09-5cacb1ea32e7a.mp4 冰品|超商|馬卡龍冰淇淋|銅鑼燒冰淇淋2019-04-09 21:41:34